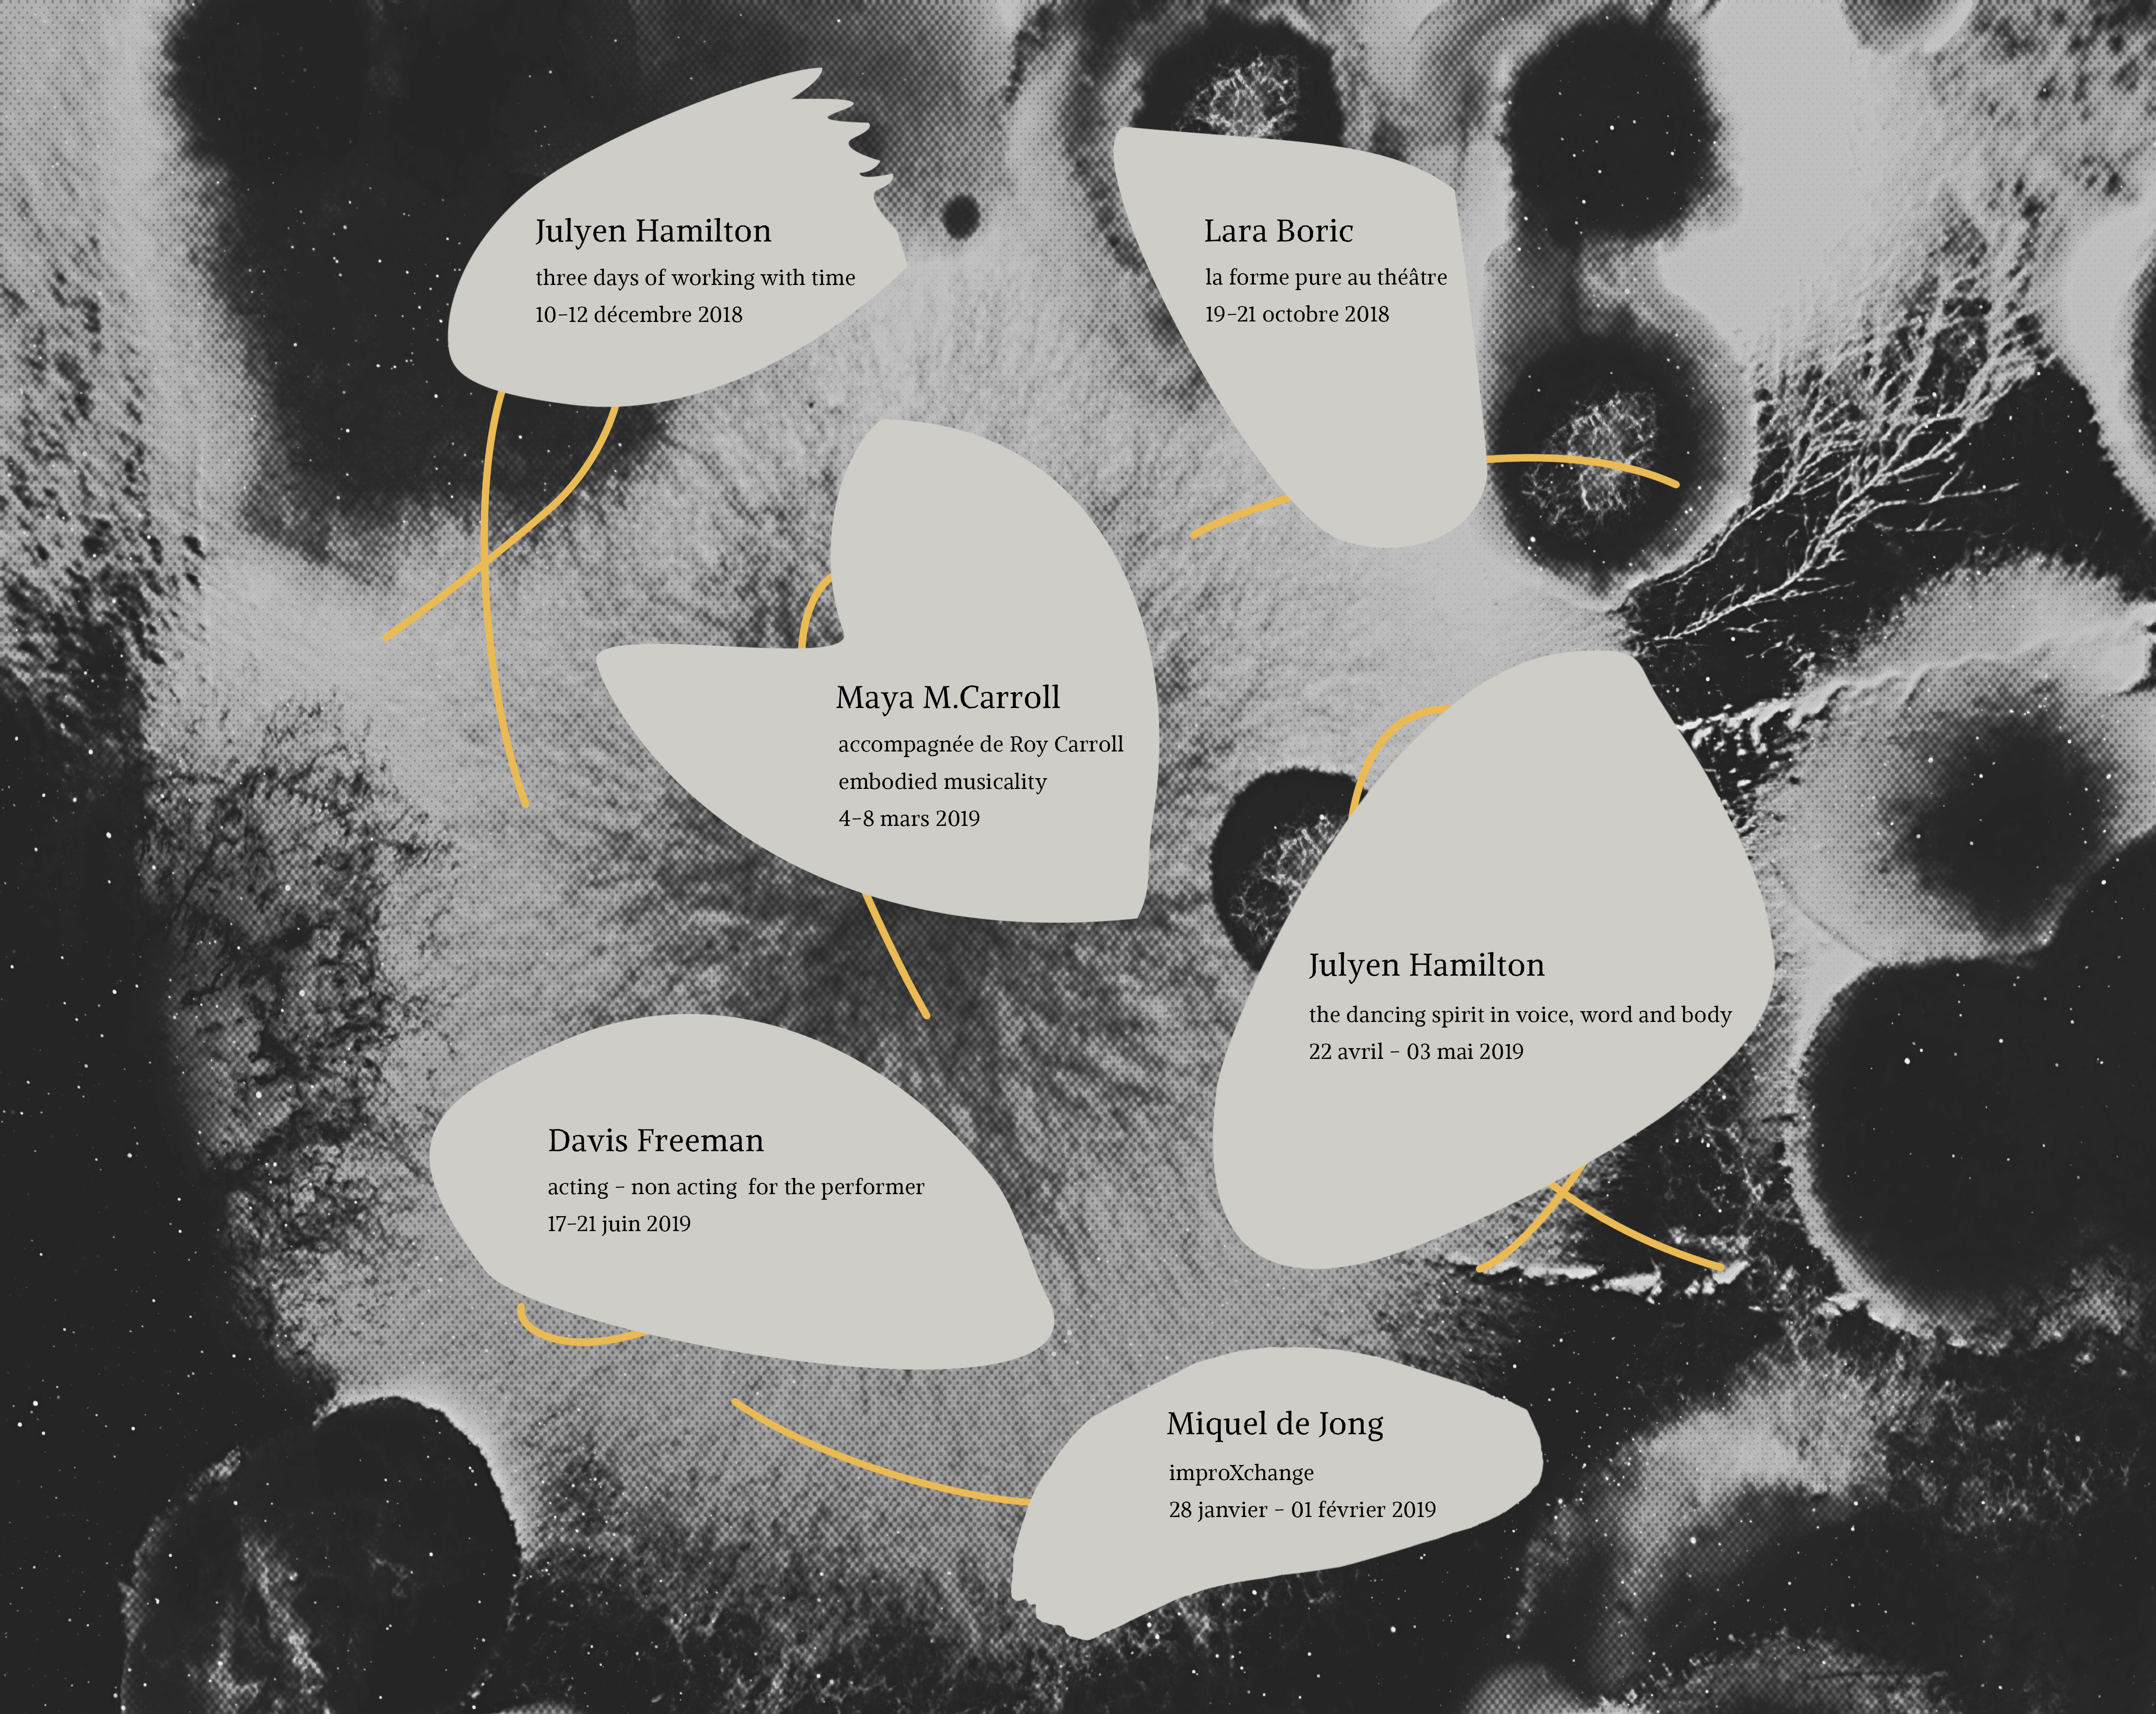

Miquel de Jong (Pays-Bas, 1971), a étudié au Conservatoire Royal de la Haye depuis l’âge de 10 ans et obtient son diplôme en 1989. Après avoir travaillé 6 ans pour le Scapino Ballet Rotterdam, il arrive en France en 1995 où il travaille comme premier soliste pour l’Opéra de Lyon, dirigé alors par Yougos Loukos, et travaille pour de grands chorégraphes tels que William Forsythe, Jiri Kylian, Mats Ek et Ohad Naharin. En 2002, Miquel commence à travailler auprès d’Angelin Prejlocaj avant de rencontrer Russel Maliphant en 2003, dont le travail jouera un rôle majeur dans son parcours. Il décide de s’établir à Londres où il appréhende des pratiques diverses et variées : Improvisation, Contact Improvisation, Capoeira, Acrobaties, Yoga, Taichi, Rolfing (fascia thérapie), et méditation. Il découvre alors une passion pour l’enseignement de l’improvisation et développe sa propre méthode, qui s’établit en deux parties : le mouvement pré-réflexif et la composition de consensus. Cette dernière s’est développée et a donné lieu a de nombreuses performances issues de l’ImproXchange. Miquel est aujourd’hui assistant de nombreux chorégraphes et metteurs en scène, et enseigne non seulement dans les écoles supérieures de danse mais aussi dans les départements de musique et de cirque. Ses workshops sont reconnus dans le monde entier.
Son parcours de danseur
Conservatoire Royal de La Haye (1981-1989)
Formations en danse classique, contemporaine, moderne, danse de caractère, pas de deux et répertoire de la Netherlands Dance Company.
Professeurs marquants : Francis Sinceretti, Marian Sarstad, Jan Nuits, Benjamin Harkarvy, Christine Anthony, Kathy Bennett, James Vincent et Tom Bosma.
Diplômé en 1989.
Compagnies de danse internationales
Ballet de l’Opéra National de Lyon (1996-2002)
Directeur : Yourgos Loukos
Ballet Prejlocaj (2002-2003)
Directeur : Angelin Prejlocaj
Compagnie Russel Maliphant (2003-2005)
Directeur : Russel Maliphant
Compagnies de danse hollandaises
Scapino Ballet Rotterdam (1989-1996)
Directeurs : Nils Christe / Ed Wubbe
Panama Pictures (2006-Present)
Directrice : Pia Meuthen
Danseur freelance (Depuis 2005)
A travaillé sous la direction de Pia Meuthen, Peut Rogie, Estefania Miranda, Jens Van Daele, Jan Martens, Klaus Jürgens, Piet Rogie, Alize Zandwijk, Joachim Slömmer, Frédéric Flamand, Meryl Tankard
Pièces dansées
William Forsythe (Step Text; Second Detail; Quartette)
Ohad Naharin (Black Milk; Tabula Rasa)
Jiri Kylian (Petite Mort; Stamping Ground; Un Ballo; Sechs Danze)
Mats Eck (Carmen, rôle de Don Jose)
Angelin Prejlocaj (Roméo et Juliette, rôle de Roméo; le Sacre du Printemps; Helicopter)
Russel Maliphant (Critical Mass; Choice; One Part II; Barbican Project)
Maguy Marin (Cendrillon; Grosse land; Contrast)
Itzik Galili (Peruriem; Ma’s Bandage)
Tero Saarinnen (Sini)
Ed Wubbe (Romeo & Julia; Parts; Rameau; Edges)
Pia Meuthen (Odd; Go tell the woman (we’re leaving); Strangely familiar; Egens dichtbij; Man and knifes; Familiar Strangers; Off track; Road to Panama; Pop up)
Son parcours de direction
Chorégraphe et Directeur artistique
ImproXchange - Ateliers et Performances (2003 à aujourd’hui)
Directeur Artistique de de Movers (2011 à aujourd’hui)
Directeur Artistique de 2movedc (2005-2011)
Assistant et coach en danse, théâtre et cirque contemporain
Pia Meuthen / Panama Pictures
Nude (2010)
Skin (2011)
Ergens Dichtbij (2013)
Alpha (2015)
Alize Zandwijk / RO theatre
Hondsdagen (2010/2011)
Vreugdetranen (2012/2013)
Gaunerstuk (2014/2015)
Peter Kramer / RO theatre
Woef Side Story 2012/2013
Enseignant et intervenant pour stage, ateliers et masterclass en Composition Instantanée
A enseigné à :
Codarts Institute of the Arts, Fontys Institute of the Arts, Artez Institute of the Arts, Amsterdam Institute of the Arts, Dansateliers Rotterdam, Production House Brabant, DANSHUIS Stationzuid, Dance Company De Stilte
Méthode ImproXchange
En atelier :
The Place (London, UK), Middlesex University (London, UK), Dance East (Ipswich, UK), Pékin, Shanghai, Kunming, Shenzhen, Canton, Hunan, Zhuhai, Chengdu et Nankin (Chine), Damas (Syrie), Tirana (Albanie), Saint-Pétersbourg (Russie), Astana et Almaty (Kazakhstan), Yeravan (Arménie), Nijni Novgorod (Russie), Lodz (Pologne), Murcia et Vigo (Espagne), Paris
En performances :
Impro Exchange, Maison culturelle hollandaise pour l’exposition universelle de Shanghai (2010)
A Chronicle by Mister X, Guangdong Modern Dance Company, à Canton, Chine (2011)
Formations spécifiques à l’improvisation
Miquel s’est notamment formé auprès de Julyen Hamilton, Michael Schumacher, Kirstie Simson et Hildegard Draaijer
Diplômes
Rolfing Structural Intergration
Advanced Rolfing Structural Integration
Rolfing Movement
Reiki
Cranial Sacral Therapy
Source point Therapy
Intérêts
Improvisation, Contact Improvisation, Yoga, Arts Martiaux, Acapoeira, Coaching pour compagnies de danse et de cirque, photographie et vidéo.